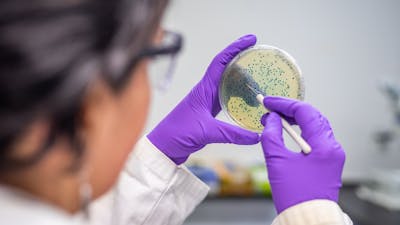

Despite the clear biological impact of the vaginal microbiome on women’s health, there are no practical diagnostics for vaginal bacterial composition, which limits clinical care and research. We plan to develop a rapid diagnostic platform to identify key vaginal microbial community members and categorize its diversity, enabling researchers and clinicians to better understand variations in vaginal health and disease. Working collaboratively, we are planning to conduct tests in Boston, MA, and Durban, South Africa, to gauge efficacy and enable us to streamline the process for eventual widespread point-of-care use.
CRISPR-Based Vaginal Microbiota Diagnostic
A rapid diagnostic platform focused on the vaginal microbiome, a driver of women’s health outcomes
Join us as we reimagine women’s health
We’re seeking passionate supporters to help advance our groundbreaking research.
Project Stage
Wyss Northpond Director’s Fund
Team
Join us as we reimagine women’s health
We’re seeking passionate supporters to help advance our groundbreaking research.
Join us as we reimagine women’s health
We’re seeking passionate supporters to help advance our groundbreaking research.